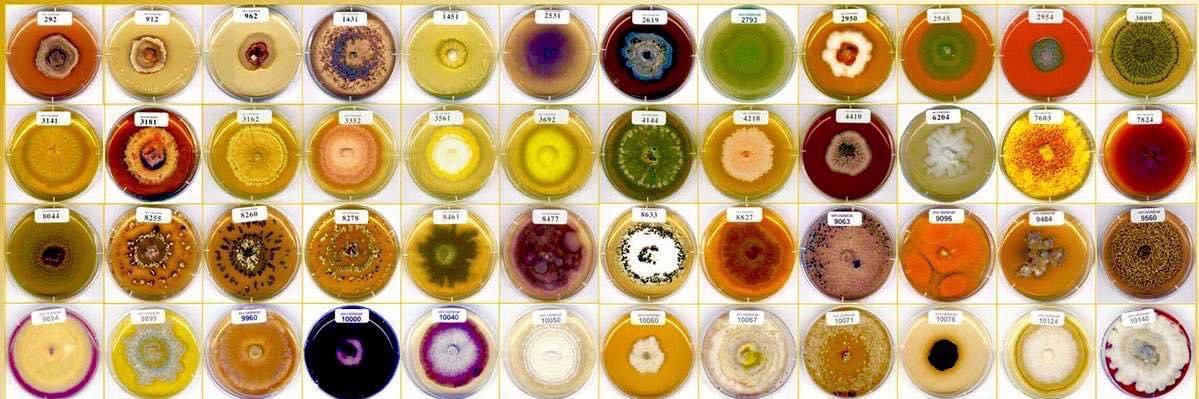
Al 🔬 banner

¡Qué momento! 🤩 Este fue el momento en el que el árbitro pitó el final del encuentro y Cruz Azul se convirtió en CAMPEÓN de la #LigaBBVAMX
Al 🔬
15.7K posts

@Al_HHz
μ-biólogo 🧫 Algo de ciencia, de Historia, a veces fut y foot 🦊🏈 ¡👆🏽la Máquina Celeste del Cruz Azul! ⭐️ 🚂 💙 La mayoría de veces, sólo memes.

¡Qué momento! 🤩 Este fue el momento en el que el árbitro pitó el final del encuentro y Cruz Azul se convirtió en CAMPEÓN de la #LigaBBVAMX





















🇲🇽🚨Esto tiene que ser un escándalo nacional, porque solo así este gobierno voltea a ver los casos. Anaid Belén Ramírez denunció que un malandrillo maltrataba a sus perros. ¿Qué hizo el Ministerio Público? No la protegió… le dio el pitazo al agresor. El resultado: la levantaron y la asesinaron a golpes junto con sus perros. Así de podrido está todo. ¿Y todavía preguntan por qué los criminales actúan así? Porque se saben intocables, porque están empoderados y porque confían plenamente en la ineptitud e impunidad de este pto gobierno de merda.









En el Estado de México asesinaron a una señora que había sido víctima de amenazas, y la “autoridad” nunca la ayudó; es más, la pusieron. Desde Noviembre del año pasado había denunciado a un pendejo que le maltrataba a sus perritos. En la Fiscalía le dieron el pitazo al hijo de puta de que la señora lo había ido a denunciar, y en venganza éste regresó a casa de ella y se la llevó a la fuerza junto con sus perritos. La hallaron muerta. Que se conozca el rostro de ese asesino hijo de puta y que nunca más viva tranquilo. Pinche sociedad de mierda.

